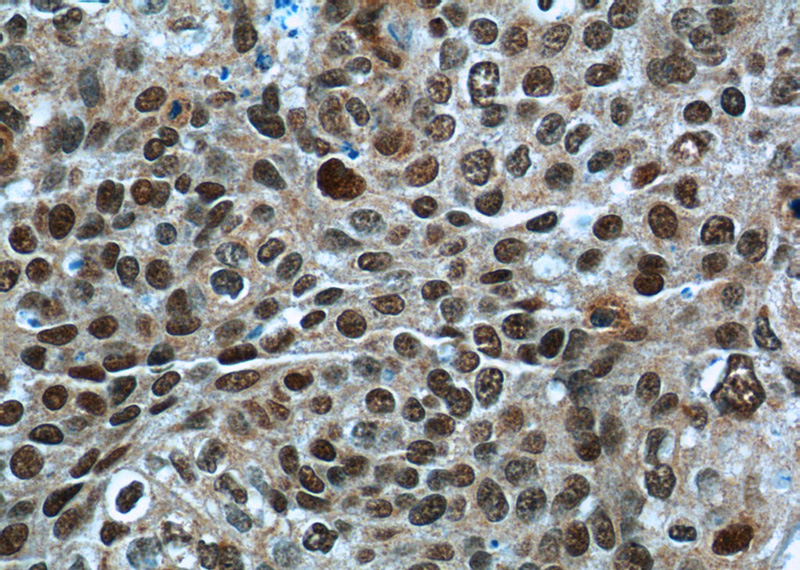
Immunohistochemistry of paraffin-embedded human cervical cancer tissue slide using Catalog No:111501(HNRNPA2B1 Antibody) at dilution of 1:50 (under 40x lens)
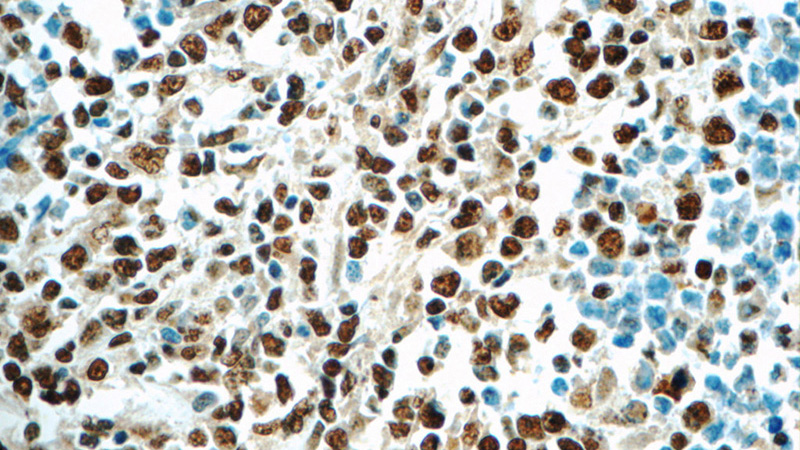
Immunohistochemistry of paraffin-embedded human lymphoma tissue slide using Catalog No:111501(HNRNPA2B1 Antibody) at dilution of 1:50 (under 40x lens)

-
Product Name
HNRNPA2B1 antibody
- Documents
-
Description
HNRNPA2B1 Rabbit Polyclonal antibody. Positive WB detected in HL-60 cells, A549 cells, HeLa cells, Jurkat cells, K-562 cells, Raji cells. Positive IP detected in mouse liver tissue. Positive IHC detected in human lymphoma tissue, human cervical cancer tissue. Positive IF detected in HeLa cells. Observed molecular weight by Western-blot: 36 kDa and 38 kDa
-
Tested applications
ELISA, WB, IHC, IP, IF
-
Species reactivity
Human,Mouse,Rat; other species not tested.
-
Alternative names
DKFZp779B0244 antibody; FLJ22720 antibody; hnRNP A2/B1 antibody; HNRNPA2 antibody; HNRNPA2B1 antibody; HNRNPB1 antibody; HNRPA2 antibody; HNRPA2B1 antibody; HNRPB1 antibody; RNPA2 antibody; SNRPB1 antibody
-
Isotype
Rabbit IgG
-
Preparation
This antibody was obtained by immunization of HNRNPA2B1 recombinant protein (Accession Number: BC000506). Purification method: Antigen affinity purified.
-
Clonality
Polyclonal
-
Formulation
PBS with 0.02% sodium azide and 50% glycerol pH 7.3.
-
Storage instructions
Store at -20℃. DO NOT ALIQUOT
-
Applications
Recommended Dilution:
WB: 1:500-1:5000
IP: 1:200-1:2000
IHC: 1:20-1:200
IF: 1:50-1:500
-
Validations

HL-60 cells were subjected to SDS PAGE followed by western blot with Catalog No:111501(HNRNPA2B1 antibody) at dilution of 1:400

IP Result of anti-HNRNPA2B1 (IP:Catalog No:111501, 4ug; Detection:Catalog No:111501 1:500) with mouse liver tissue lysate 4000ug.
Immunohistochemistry of paraffin-embedded human cervical cancer tissue slide using Catalog No:111501(HNRNPA2B1 Antibody) at dilution of 1:50 (under 40x lens)
Immunohistochemistry of paraffin-embedded human lymphoma tissue slide using Catalog No:111501(HNRNPA2B1 Antibody) at dilution of 1:50 (under 40x lens)

Immunofluorescent analysis of (10% Formaldehyde) fixed HeLa cells using Catalog No:111501(HNRNPA2B1 Antibody) at dilution of 1:50 and Alexa Fluor 488-congugated AffiniPure Goat Anti-Rabbit IgG(H+L)
-
Background
HnRNPA2B1 in one of heterogenous nuclear ribonucleoproteins (HnRNPs), which regulate the splicing and transportation of mRNA and participate in growth regulation and carcinogenesis. It has a role in packaging nascent mRNA, alternative splicing, tycoplamic RNA trafficking, translation and stabilization. Besides it may involve in telomere maintenance, cell proliferation and differentiation, and glucose transport. Gene HURNPA2B1 encode two protein, HNRNPA2 (38kd) and HNRNPB1 (36kd), by alternative splicing.
-
References
- Guo R, Li Y, Ning J, Sun D, Lin L, Liu X. HnRNP A1/A2 and SF2/ASF regulate alternative splicing of interferon regulatory factor-3 and affect immunomodulatory functions in human non-small cell lung cancer cells. PloS one. 8(4):e62729. 2013.
- Cho KI, Patil H, Senda E. Differential loss of prolyl isomerase or chaperone activity of Ran-binding protein 2 (Ranbp2) unveils distinct physiological roles of its cyclophilin domain in proteostasis. The Journal of biological chemistry. 289(8):4600-25. 2014.
- Suzuki H, Shibagaki Y, Hattori S, Matsuoka M. Nuclear TDP-43 causes neuronal toxicity by escaping from the inhibitory regulation by hnRNPs. Human molecular genetics. 24(6):1513-27. 2015.
- Cho KI, Orry A, Park SE, Ferreira PA. Targeting the cyclophilin domain of Ran-binding protein 2 (Ranbp2) with novel small molecules to control the proteostasis of STAT3, hnRNPA2B1 and M-opsin. ACS chemical neuroscience. 6(8):1476-85. 2015.
Related Products / Services
Please note: All products are "FOR RESEARCH USE ONLY AND ARE NOT INTENDED FOR DIAGNOSTIC OR THERAPEUTIC USE"
